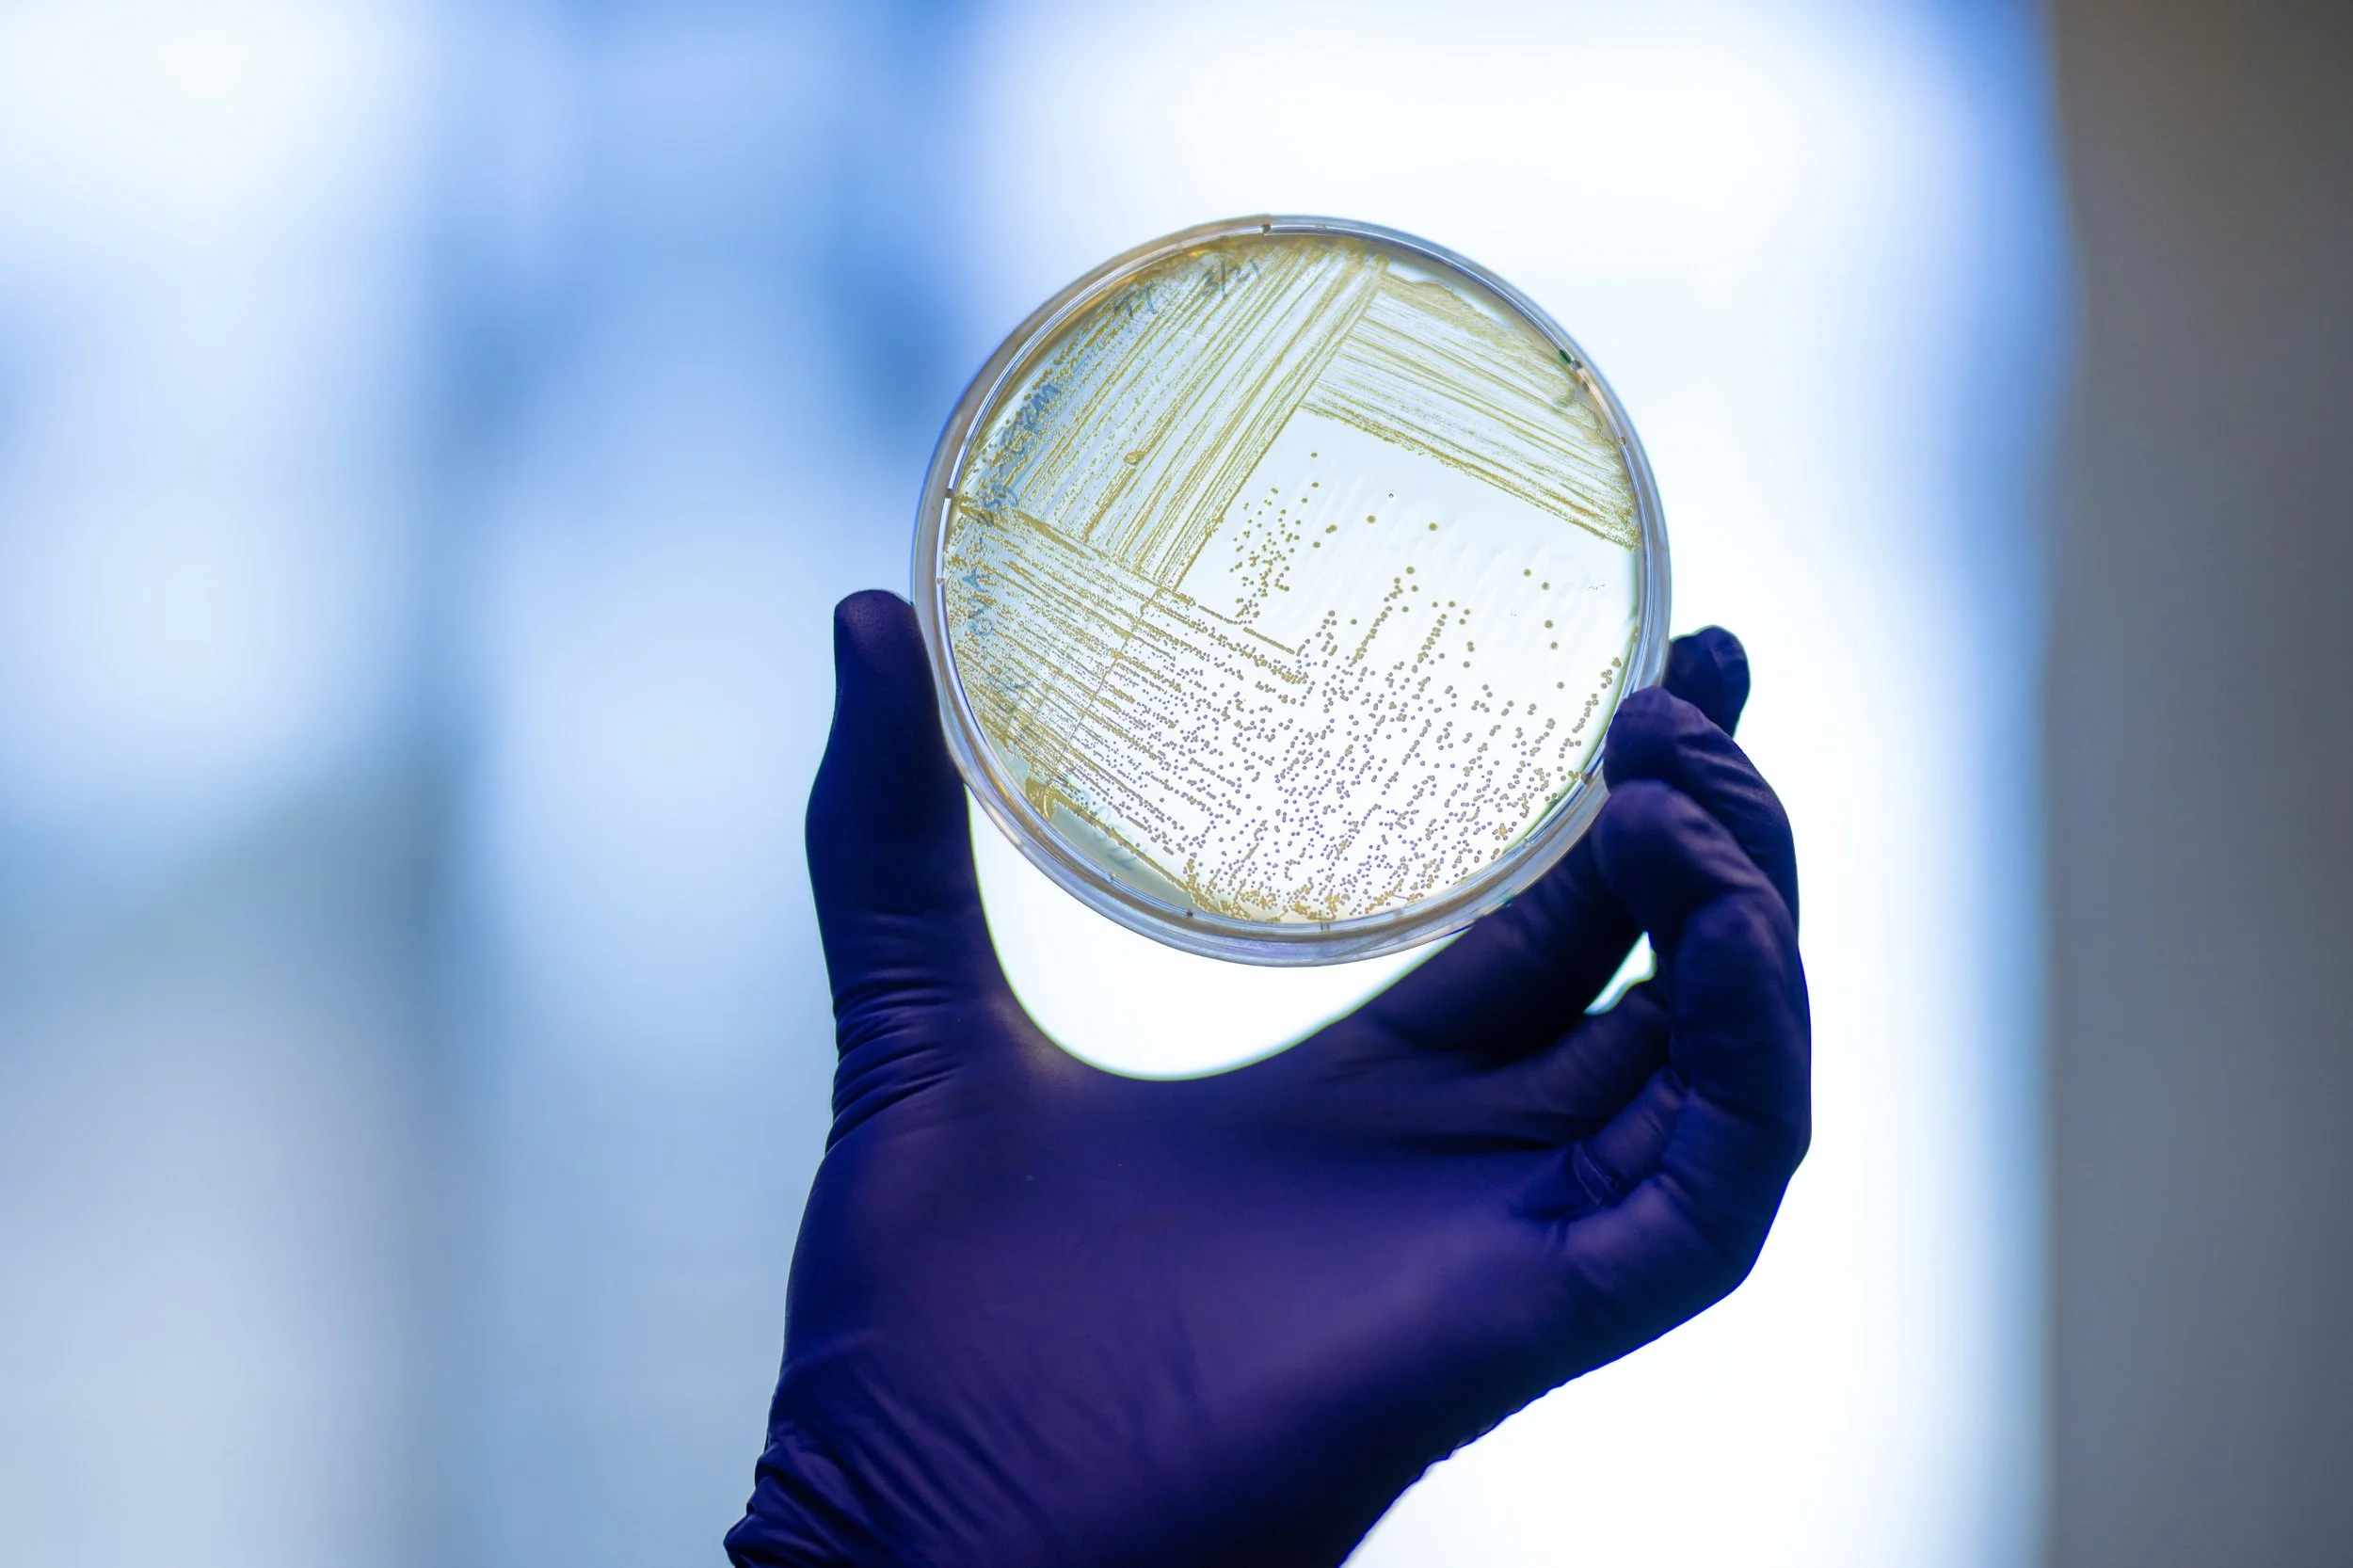

UCSF Photography
Role: Art Director, Creative Director
I partnered with the UCSF Office of Communications to elevate their extensive photography library. This wasn't just about managing files; it involved everything from creative direction for custom photo shoots to developing seamless workflows and robust file management solutions. We helped them capture and maintain a visual archive that authentically tells their story.